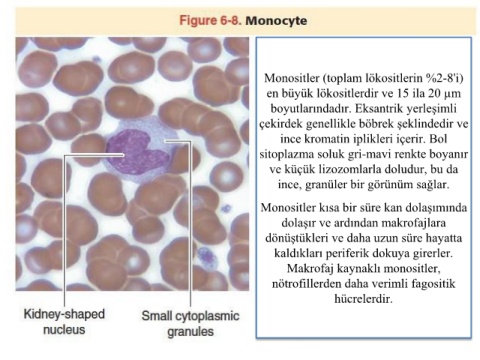

Page 65 - Periferik Kan Hücreleri-Dr. Öğr. Üyesi Tuğçe Önel Dönem 2
P. 65
Monositler (toplam lökositlerin %2-8'i)
en büyük lökositlerdir ve 15 ila 20 µm
boyutlarındadır. Eksantrik yerleşimli
çekirdek genellikle böbrek şeklindedir ve
ince kromatin iplikleri içerir. Bol
sitoplazma soluk gri-mavi renkte boyanır
ve küçük lizozomlarla doludur, bu da
ince, granüler bir görünüm sağlar.
Monositler kısa bir süre kan dolaşımında
dolaşır ve ardından makrofajlara
dönüştükleri ve daha uzun süre hayatta
kaldıkları periferik dokuya girerler.
Makrofaj kaynaklı monositler,
nötrofillerden daha verimli fagositik
hücrelerdir.